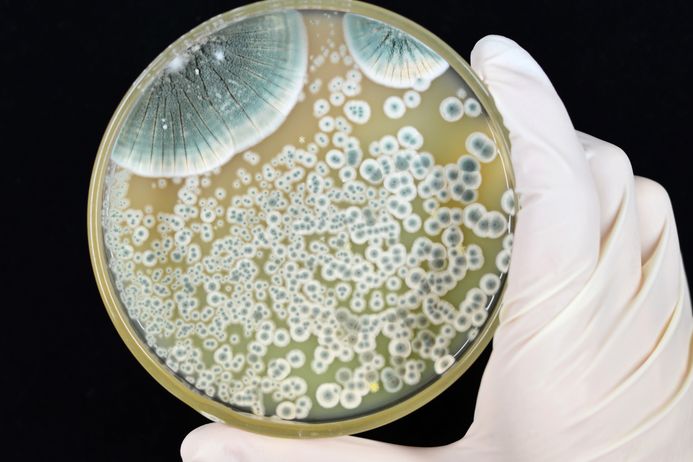

Azka Asif

Role: PhD student at the Institute of Pharmaceutical Sciences at King’s College London and a Commonwealth Scholar
Subject area: Faculty of life sciences and Department of Cancer and Pharmaceutical Sciences
Nationality: Pakistani
I have been working as a postgraduate researcher at King’s College London Institute of Pharmaceutical Sciences for more than two years. I am studying bacterial genes and their role in infections. I started my research journey when I was enrolled in my undergraduate course. This helped me develop my interest and skills as a researcher in biological sciences quite early on.
Education
![]()
GCSEs (or equivalent): High school in Pakistan with subjects Physics, Chemistry, Mathematics, Biology, English and Social Science
A-level (or equivalent): Pre-Medical with Physics, Chemistry, Biology, and English
Degrees
• BSci (Honors) Microbiology and Molecular Genetics, University of the Punjab, Lahore, Pakistan
• MPhil Biological sciences (specialisation in Molecular Microbiology), University of the Punjab, Lahore, Pakistan
Detail about Azka
My research
I study bacterial genes and their role in virulence regulation, the mechanisms by which pathogens, such as bacteria or viruses, control their ability to cause disease in a host. Bacterial genes are stretches of DNA that possess regulatory sequences to control severity of a disease and normal physiology. Thus, understanding of the host-microbe interactions is useful in disease management and prognosis.
My inspiration
While I was growing up, the suffering of people at the hands of poor disease management systems made me realise the need to improve the quality of life.
Who is your STEM hero?
Rosalind Franklin was a chemist, and her work formed our understanding of the molecular structures of nucleic acid materials, DNA and RNA as well as viruses.
Most significant discovery/invention?
The discovery of penicillin, which lead to the discovery of thousands of antimicrobials we use today.

Career options after study
A degree in Microbiology can equip you with skills to go into a career of pharmaceuticals, diagnostics, forensics, and clinical research.

My hobbies
In my spare time I like playing cello, watching movies, going out with friends, and reading books.